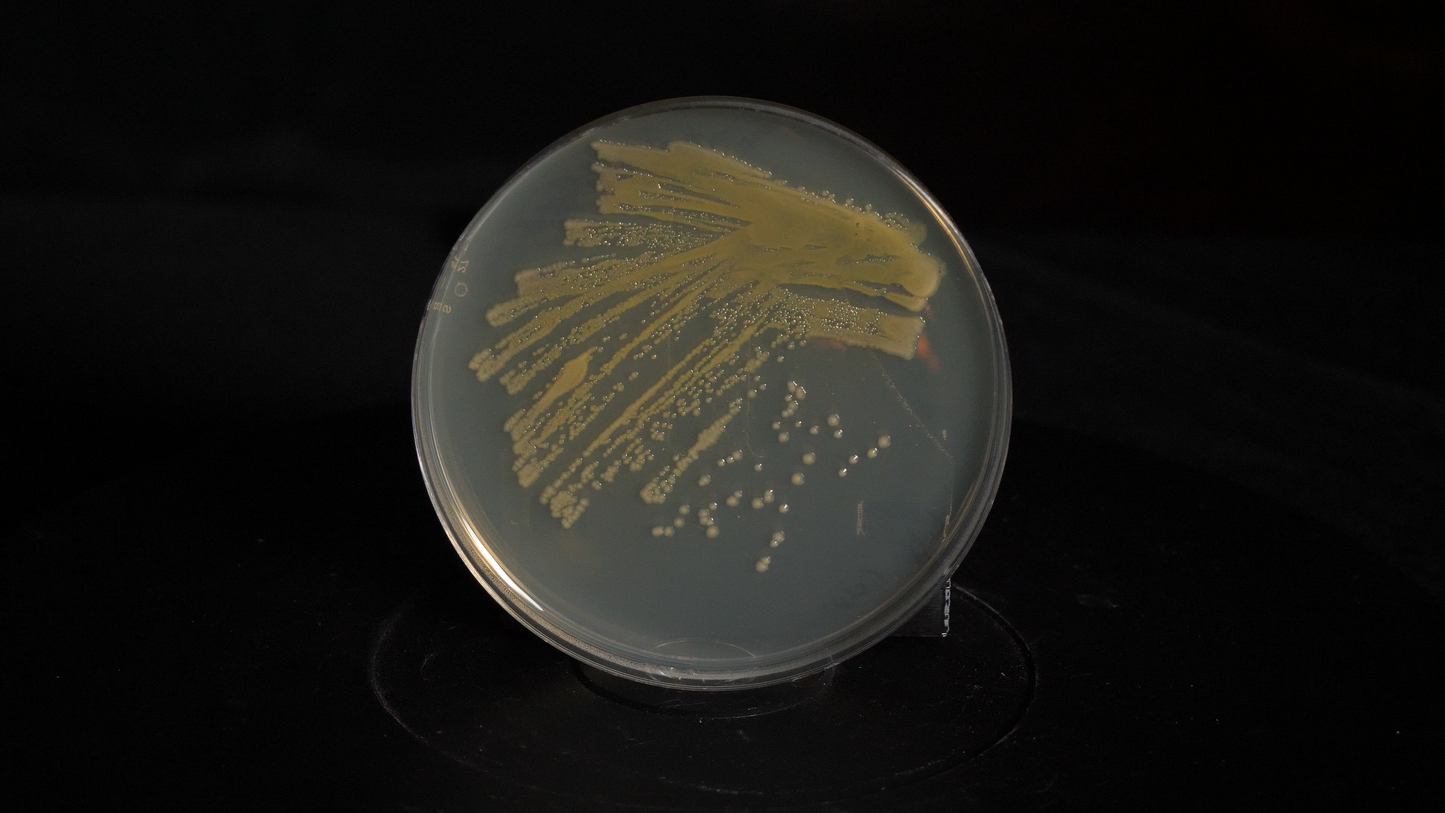

1
/
of
2
The Thought Emporium
DH5A E. coli | Agar Stab
DH5A E. coli | Agar Stab
Regular price
$72.50 CAD
Regular price
Sale price
$72.50 CAD
Unit price
/
per
Shipping calculated at checkout.
Couldn't load pickup availability
This listing is for E. coli strain DH5a. It is a BSL1 organism and is an extremely popular lab strain. It is easy to transform, grows quickly, and has reasonable protein production ability.
It is ideal for working in the lab and molecular biology, as well as DNA handling.
If you need a protocol for making the bacteria calcium competent, see our latest video: LINK
The bacteria are provided as an agar stab and must be shipped express. Stabs can be stored at room temperature, but for maximum shelf life, store in the fridge at ~5C.
Share